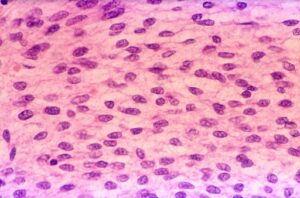
Стовбурові клітини жирової тканини: що це таке?-1

Одним з найсучасніших напрямів в багатьох областях сучасної медицини є клітинна терапія. Основними джерелами стовбурових клітин є червоний кістковий мозок і жирова тканина. У цій статті мова піде про перспективи отримання стовбурових клітин (СК) з власного жиру людини.
Що таке «мезенхіма»?
Жирова тканина починає формуватися ще з ембріональних сполучних волокон, які разом називаються «мезенхіма». Жир дорослої людини складається зі спеціальних клітин, властивих тільки йому. Переважно вони складаються з опорної структури органів, яка називається строма. Саме в ній і були виявлені стовбурові клітини (СК). Багато в чому їх будова нагадує структуру стовбурових клітин кісткового мозку.
Ефективність стовбурових клітин жирової тканини
Стовбурові клітини, видобуті з жиру, мають значні переваги перед своїми побратимами з кісткового мозку:
 Протягом 1,5 місяців після ін’єкцій відновлюють функції печінки і покращують процес кровотворення
Протягом 1,5 місяців після ін’єкцій відновлюють функції печінки і покращують процес кровотворення- Комплексно впливають на нормалізацію роботи нервової, судинної і ендокринної систем
- Мають нульовий відсоток відторгнення і ризиків, пов’язаних з використанням донорських тканин
- Дозволяють уникнути болючих маніпуляцій зі забору клітин – процедуру проводять під місцевою анестезією
- Також вони мають високий регенераторний потенціал, тобто можуть відтворювати потрібні клітини
Перспективи застосування
Результати досліджень, які були опубліковані в журналі Cell в 2010 році, показали, що велика кількість стовбурових клітин міститься саме в жировій тканині та слугує для накопичення запасів регенераційного потенціалу багатьох тканин нашого тіла, а саме: хрящової тканини, шкіри, кров’яних клітин і кровоносних судин.
Стовбурові клітини жирової тканини ідеально підходять для лікування артриту, артрозу, остеохондрозу і захворювань зв’язок, сухожиль і суглобів. Також цей метод лікування застосовується для пацієнтів з травматичними дефектами хряща. Результати показали, що у людей з дегенеративними хворобами суглобів після застосування клітинної терапії відбувається істотне зниження больового синдрому і відновлюється хрящова поверхня. Відповідно, це підвищує якість життя, зменшує необхідність прийому знеболюючих засобів, а головне – на тривалий час відкладає операцію зі заміни суглоба на штучний.
Стовбурові клітини жирової тканини застосовують не тільки в ортопедії або травматології. У світі їх використовують при лікуванні ран, судинних хвороб і навіть при ураженнях нервової системи. Крім цього, вони ефективні в косметології для омолодження шкіри.
Варто зазначити, що на території інституту передової медицини VIRTUS знаходиться власна сертифікована біотехнологічна лабораторія Smart Cell. Наші біологи вміють вирощувати стовбурові клітини з жирової тканини, які потім застосовуються для лікування цукрового діабету та вирішення багатьох проблем в області естетичної медицини.






 6342
6342  1 хв.
1 хв.